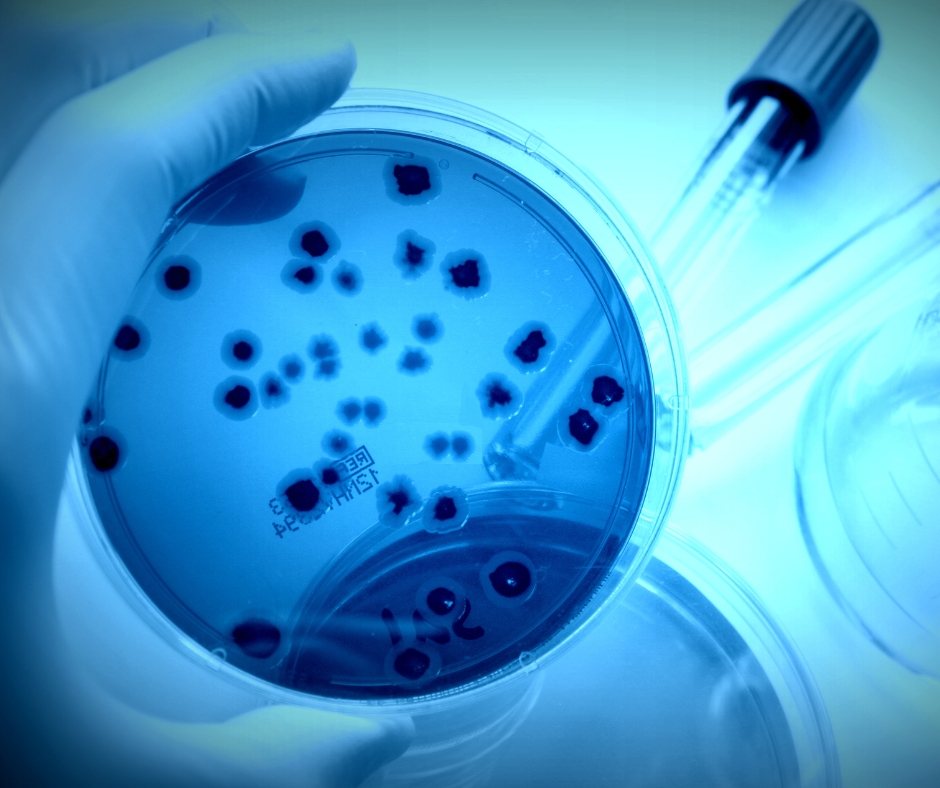
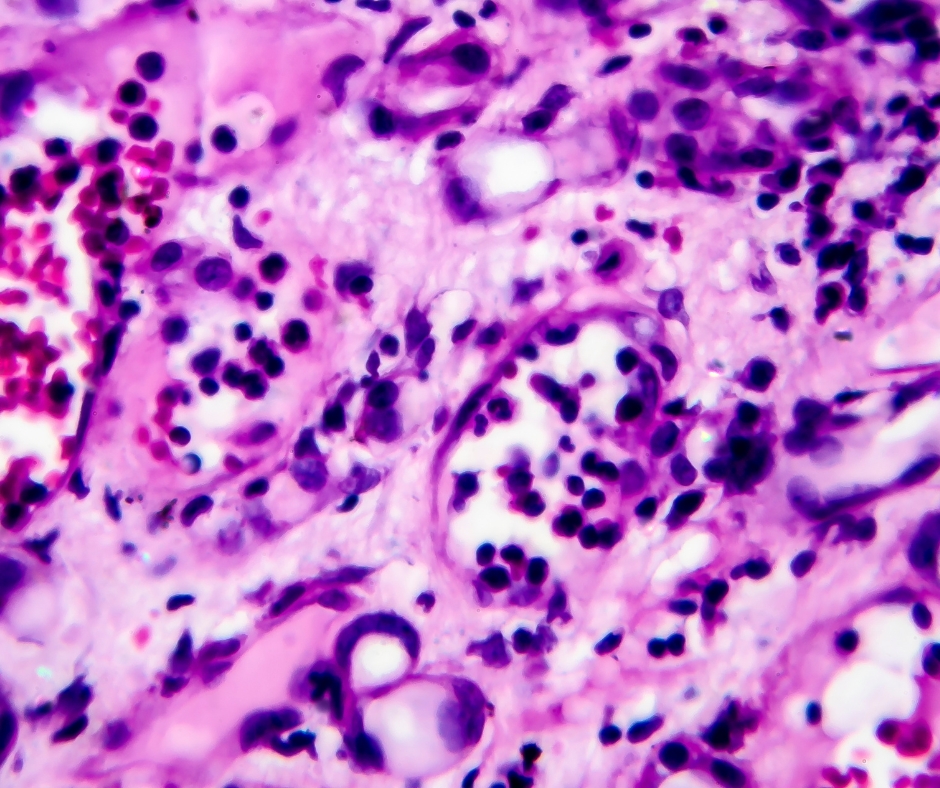

Expertise
Our Expertise

"Harness the power of Hematology to help you understand and manage your blood health. Get the answers you need for a healthier, happier you!"
Hematology

"Unlock the secrets of life with Biochemistry - the science of understanding how molecules work together to create the most complex systems known to man!"
Biochemistry

Serology: Get accurate, reliable, and timely results for your medical and research needs. #Serology #AccurateResults #ReliableTesting
Serology

S"Clinical Pathology is the key to unlocking the secrets of the body and understanding your health. With its comprehensive approach to diagnostics.
Clinical Pathology

"Unlock the mysteries of your immune system with Immunology - the essential guide to understanding your body’s first line of defense!"
Immunology
"Discover the fascinating world of Microbiology! Unlock the secrets of lif and explore the microscopic universe with our comprehensive courses!"
Microbiology

"Discover the power of the FNAC Test: get accurate results and reliable insights for a better understanding of your health!"
FNAC
"Discover the power of Histopathologyand gain deeper insights into patient health - get the answers you need for more accurate diagnosis and treatment!"